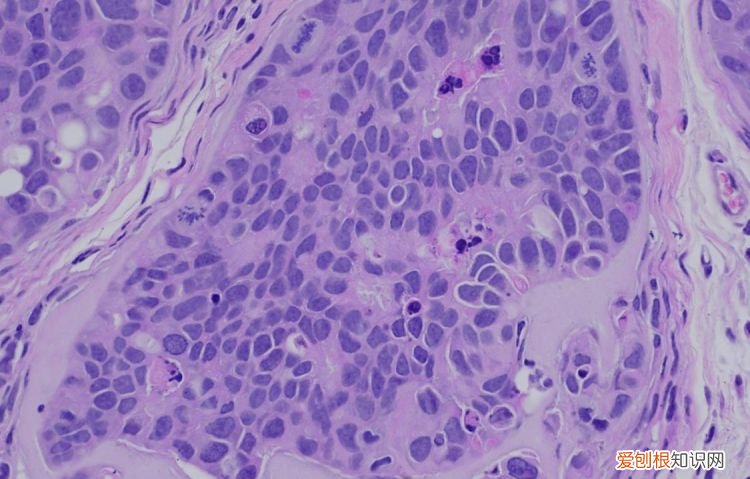
he染色原理是什么，he染色方法什么叫he染色法呢

四、返蓝作用:
分化之后,苏木精在酸性条件下处于红色离子状态,呈红色,在碱性条件下处于蓝色离子状态,呈蓝色 。组织切片经0.5%盐酸乙醇分化后呈红色或粉红色,故分化之后,立即用水除去组织切片上的酸而终止分化,再用弱碱性水(0.2%氨水)使苏木精染上的细胞核呈现蓝色,这个过程称为返蓝作用或蓝化作用 。另外用自来水浸洗也可使细胞核返蓝,但所需时间较长 。
实验材料
固定液:常用95%乙醇和冰丙酮
苏木精染液:称取苏木精粉0.5g,铵矾24g溶解于70ml蒸馏水中,然后取NaIO 31g,水5ml,再加入甘油30ml和冰醋酸2ml,混合均匀,滤纸过滤,备用 。
伊红染液:称取0.5g水溶性伊红染液,溶于100ml蒸馏水中 。
稀盐酸乙醇溶液:用75%乙醇配制1%盐酸 。
系列浓度的乙醇、二甲苯、中性树胶 。
培养瓶、培养皿、眼科镊、盖玻片、载玻片、显微镜 。
实验步骤
样品制备:对于贴壁生长细胞,胰酶消化,调整细胞浓度约1×105/ml,滴加于盖玻片上(置于6孔板中),培养相应时间后,取出细胞爬片,用PBS 洗涤3次 。
样品固定:95%乙醇固定20min,PBS洗涤2次,每次1min 。
染核:苏木素染液染色2-3min,自来水洗涤 。
分色:镜下观察,若细胞核染色过深,用1%盐酸酒精溶液分色数秒,自来水洗涤 。
染胞质:浸入伊红染液染色1min,自来水洗涤 。
吹干或自然晾干细胞 爬片后,中性树胶封片 。
若细胞用4%多聚甲醛固定,则染色时间相应延长,苏木素染色12-15min,伊红5min即可 。
实验结果及注意事项
** 实验结果**
细胞核呈蓝色,细胞质,肌纤维,胶原纤维和红细胞呈不同程度的红色 。钙盐和细菌可呈蓝色或紫蓝色
注意事项:
1. 染色时调节pH值很重要 。如果组织块在福尔马林中固定时间长,组织酸化而影响细胞核着色 。因此,要在自来水中冲洗时间长一些或在饱和碳酸锂水溶液中处理10-30min,这样可以使细胞核着色较深 。染伊红时胞浆着色不佳,可在伊红溶液中滴加1-2滴冰醋酸 。
2. 切片染苏木精后,分色这一步是关键,应在显微镜下控制进行,一般以细胞核染色清楚(晰)而细胞质基本无色为佳 。如果过分延长分色时间将导致染色太浅,应重新染色后再行分色 。
3. 切片经酒精脱水后,入二甲苯时可出现白色不透明状态,此为脱水不彻底,应将切片退回无水酒精,更换酒精、二甲苯,以求彻底脱水与透明 。
文章插图
【he染色原理是什么,he染色方法什么叫he染色法呢】以上就是关于he染色原理是什么,he染色方法什么叫he染色法呢的全部内容,以及he染色原理是什么的相关内容,希望能够帮到您 。
推荐阅读
- 动车d开头和g开头是什么意思,动车d字开头和g开头是什么意思
- 朝花夕拾是什么意思 鲁迅写的朝花夕拾是什么意思
- 王者荣耀怎么更改游戏名称
- 黄金可以带着洗澡吗
- 小米手机如何使用万能遥控器
- 博比特虫有毒吗 博比特虫咬人有毒吗
- abc罩杯大小有什么区别
- 冬天的第一个包包是什么意思 冬天第一个包啥意思
- 木质地板怎么安装


